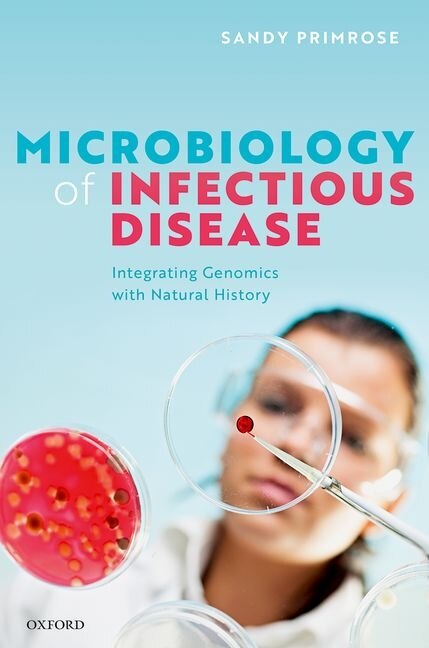

Home
Microbiology of Infectious Disease by Sandy R. Primrose, Hardcover | Indigo Chapters
Loading Inventory...
Coles
Microbiology of Infectious Disease by Sandy R. Primrose, Hardcover | Indigo Chapters
From Sandy R. Primrose
Current price: $128.04

Coles
Microbiology of Infectious Disease by Sandy R. Primrose, Hardcover | Indigo Chapters
From Sandy R. Primrose
Current price: $128.04
Loading Inventory...
Size: 25.4 x 234 x 590
*Product information may vary - to confirm product availability, pricing, shipping and return information please contact Coles
Prior to the advent of rapid DNA sequencing in the late 90s, students were taught in depth about the physiology and ecology of microorganisms. There was a generally good understanding about the biology of each organism and how it interacted with its environment. Since then, the focus ofresearch has shifted towards an analysis of nucleic acid sequences to determine possible cellular biochemistry or phylogeny. A microbial genome can now be sequenced in a matter of hours, and with the help of a panoply of software programmes the inner workings of the organism can be probed in greatdetail. However, there is now so much detail that the student or researcher tends to lose any sense of the underlying biology of their study organism. Microbiology has almost become a branch of molecular biology, with the biology getting lost in the molecular detail. This novel text reverses that trend by cutting through the molecular information overload and placing the new sequence-derived information in the context of the natural history of the organism in question. Each concise chapter has a fascinating and different story to tell, focussing on one pathogenor group of closely related pathogens and highlighting a particularly interesting and/or unusual feature. The aim is to abstract the relevant molecular and genomic information, and then to show how it provides insights into the biology of the organism as a whole. Microbiology of Infectious Disease is aimed at undergraduates, graduates, and researchers in microbiology, microbial ecology, disease ecology, and related areas. It is intended as a supplemental text for students to provide them with a detailed overview of the biology and natural history of themicroorganisms they will routinely encounter and the factors that influence their pathogenicity and infectivity. | Microbiology of Infectious Disease by Sandy R. Primrose, Hardcover | Indigo Chapters